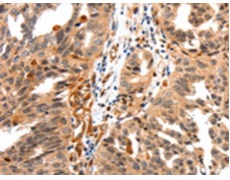
一抗

中文名稱: 兔抗GAS6多克隆抗體
|
Background: |
This gene product is a gamma-carboxyglutamic acid (Gla)-containing protein thought to be involved in the stimulation of cell proliferation, and may play a role in thrombosis. Alternatively spliced transcript variants encoding different isoforms have been found for this gene. Ligand for tyrosine-protein kinase receptors AXL, TYRO3 and MER whose signaling is implicated in cell growth and survival, cell adhesion and cell migration. GAS6/AXL signaling plays a role in various processes such as endothelial cell survival during acidification by preventing apoptosis, optimal cytokine signaling during human natural killer cell development, hepatic regeneration, gonadotropin-releasing hormone neuron survival and migration, platelet activation, or regulation of thrombotic responses. |
|
Applications: |
ELISA, IHC |
|
Name of antibody: |
GAS6 |
|
Immunogen: |
Synthetic peptide of human GAS6 |
|
Full name: |
growth arrest-specific 6 |
|
Synonyms: |
AXSF, AXLLG |
|
SwissProt: |
Q14393 |
|
ELISA Recommended dilution: |
1000-2000 |
|
IHC positive control: |
Human ovarian cancer and Human cervical cancer |
|
IHC Recommend dilution: |
10-50 |
 購物車
購物車 幫助
幫助
 021-54845833/15800441009
021-54845833/15800441009